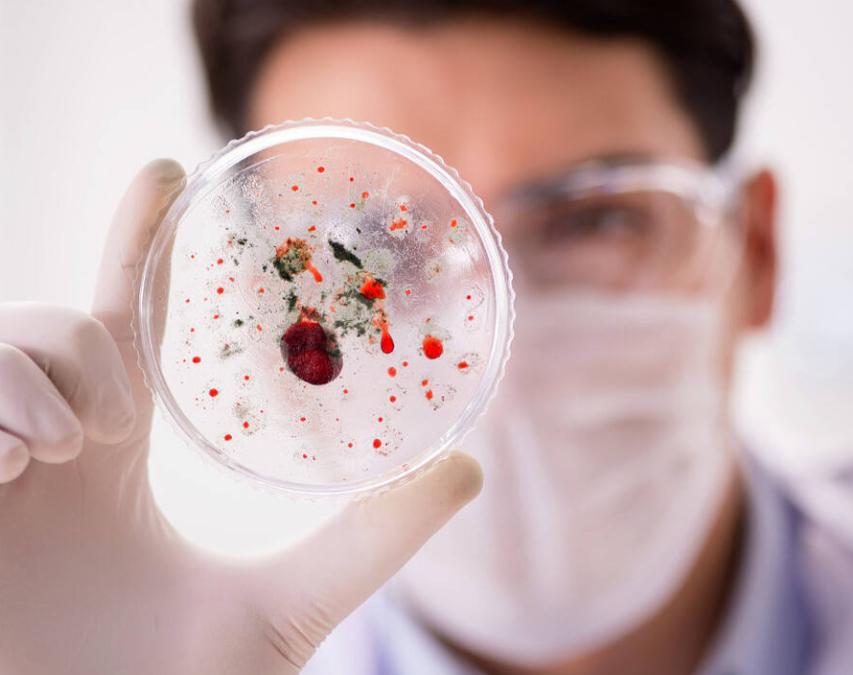
补硒后的食品()-硒宝网

补硒后的食品()

王阿姨最近常常感冒,气短乏力,甚至连做她最爱的广场舞都力不从心。儿子说“多补点钙,多吃点肉”,可她的体检查下来,钙、铁都在正常范围内。主治医生却提出了一个鲜有人问起的词:“硒元素?!?/p>
这一句话,王阿姨有点懵,这样一个微量元素,真的会影响免疫力、还能关系到防癌吗?
她心生疑问:是不是饮食没注意,才让身体“掉了链子”?而事实上,硒的作用,远比大多数人想象中要重要得多。

很多人补钙补铁,却忽视了硒的关键作用,你是其中之一吗?为什么医生越来越强调“补硒”?尤其是第2种补硒方式,很多中老年人容易忽略,结果错过了健康提升的机会。
今天,就让我们一同揭开硒的科学真相:它为什么会成为抗癌与增强免疫力的“幕后英雄”?日常补硒靠吃什么,效果才更靠谱?这几点,你一定要提前知道。
硒,是人体健康的“小螺丝钉”
硒是一种必需的微量元素,虽含量极低,但在免疫调节、抗氧化、抗癌等方面具有举足轻重的地位。
中国营养学会《2023版膳食营养素参考摄入量》指出:成年人每天应摄入60微克硒,孕妇、哺乳期女性需求更高。而根据全国营养调查,部分省份特别是土壤缺硒地区人群摄入普遍不足,轻度缺硒比例超过20%。

缺硒会带来什么隐患?
不少研究证实,长期缺硒不仅会导致免疫力下降,还可能影响心脑血管、甲状腺健康。历史上,克山病和大骨节病就是因缺硒流行于我国个别地区的。
更值得关注的是,权威刊物《中华肿瘤防治杂志》2022年发布的流行病学研究显示:硒摄入量较高者,肝癌、肺癌、食管癌的发病率分别降低了12%-23%不等。
其背后机制有二:一是硒激活谷胱甘肽过氧化物酶,能有效清除体内自由基,减少DNA受损,降低肿瘤发生概率;二是促进T细胞、巨噬细胞活性,提高免疫系统对异常细胞的识别和清除能力。
换句话说,硒就是身体“防火墙升级包”,补充到位,细胞防御能力更强,对多种慢性病有天然的抑制和保护力。

坚持补硒,1-2个月后,身体有何变化?
坚持通过饮食补充适量硒,并保持数周到数月,身体常见的3大积极变化包括:
免疫力明显提高:临床数据表明,中老年人坚持“补硒”2个月后,感冒几率下降17%-28%,反复口腔溃疡、易病困倦的状况明显改善。
抗氧化能力变强:补充硒后,血液谷胱甘肽过氧化物酶提升,机体清除自由基的速度加快,皮肤状态更稳定,细胞老化速度减慢。
癌症风险降低:多项流行病学研究发现,硒摄入高于推荐标准者,特定癌症风险(如肝癌、胃癌)出现10%以上下降趋势。硒可调节细胞凋亡、抑制肿瘤细胞扩散,为身体构建一道天然防线。
很多人并不清楚,反复感冒、皮肤暗淡、指甲易断、头发粗糙等现象,背后都可能隐藏着轻度缺硒的信号。如果你发现这些“小毛病”久治不愈,不妨做个血清硒检测,查一查自己的健康隐患。
补硒不用乱吃补品,这3种食物就够了
宣传补硒的广告满天飞,但真正安全、有效的途径,仍以食物补硒为首选。据中国食物成分表与多项科研总结,补硒的食物以富硒鸡蛋、巴西坚果、菌菇类为代表:
富硒鸡蛋:通过饲料添加富硒主粮,鸡蛋中的硒含量是普通鸡蛋的2-3倍。每日早餐一个富硒蛋,基本覆盖日需量的30-50%,皮薄清爽、易于吸收,适合绝大多数人群长期食用。
巴西坚果:天然硒含量“地表最强”,每颗果仁平均含硒68-90微克,一天一粒,就能轻松达到推荐摄入。但注意不可过量,避免硒中毒风险。

蘑菇类(香菇、平菇等):特别是富硒产区的蘑菇,其硒含量也极为丰富。与蛋白质、多糖等免疫营养成分协同作用,包括抗氧化、提升免疫等双重好处,烹饪简单、适合多人群。
食补是“最天然、最平衡”的方法,也更具科学性。比起动辄几百元的保健品,这些食物更加靠得住。每一种食物搭配摄入,长期坚持,仿佛给身体补上一块关键拼图。
科学补硒,千万别“补过头”
补硒虽好,但不是多多益善。中国成年人安全上限是每天400微克硒,超量补充反而易致脱发、恶心、指甲变形等中毒表现。
尤其是中老年慢性病患者、孕妇、儿童,补硒要根据医生建议定量实施,并注意饮食多样化、合理搭配。补硒的关键不是追求速度和量,而是“恰到好处、日日有为”。

本文为健康知识科普,结合权威资料和个人观点撰写,部分情节为方便表达和阅读理解进行了适当虚构与润色,内容仅供参考,不能替代医生诊断。如感不适,请及时就医。
参考资料:
《研究:硒是防癌、增强免疫力的关键元素,多吃3种食物就能补充》
《研究:硒是防癌、增强免疫力的关键元素,多吃这3种食物就能补充》
《研究:硒是防癌、增强免疫力的关键元素,多吃3种食物就能补充》
《再次提醒:硒是抗癌、增强免疫力的必需元素,多吃3类食物就能补》
《研究:硒是防癌、增强免疫力的关键元素,多吃5种食物就能补充》
